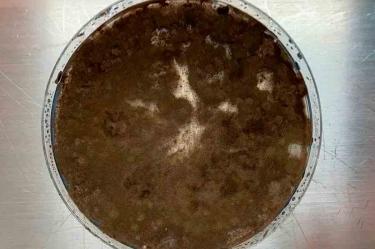
thumb

Hongo oscuro de Chernóbil podría ‘comer’ radiación y proteger a astronautas en el espacio
Un hongo negro hallado en Chernóbil no solo resiste la radiación: podría alimentarse de ella gracias a la melanina.
En medio de las ruinas de Chernóbil, donde casi nada debería prosperar, un extraño hongo negro está desafiando todas las reglas de la biología, y quizá abriendo una puerta inesperada hacia el futuro de la exploración espacial.
Te puede interesar: Lobos mutantes expuestos al desastre de Chernóbil desarrollan súper poder contra el cáncer
Se trata de un organismo que no solo tolera la radiación, sino que parece alimentarse de ella, y que está siendo estudiado por un grupo internacional de investigadores.

La BBC retomó recientemente las líneas centrales de esta curiosa aventura científica que comenzó en 1997, cuando la microbióloga ucraniana Nelli Zhdanova caminaba por la zona de exclusión de Chernóbil, y se topó con algo insólito, un moho negro creciendo felizmente en lugares donde la radiación era intensa.
Años después del desastre de 1986, que dejó 31 muertos inmediatos y miles de afectados por cáncer, la vida humana estaba vetada de la zona, pero estos hongos no solo se instalaron y parecían avanzar hacia la radiación, como si fueran atraídos por ella.
¿Por qué algo querría acercarse a la radiación?
Los estudios de Zhdanova revelaron que estos hongos, 37 especies distintas, estaban cargados de melanina, el mismo pigmento que oscurece la piel humana y la protege del sol, por lo que ella propuso que quizá esa melanina también protegía a los hongos de la radiación ionizante.
Pero las teorías se volvieron aún más sorprendentes en 2007, cuando la científica nuclear Ekaterina Dadachova, del Colegio de Medicina Albert Einstein, descubrió que los hongos se multiplicaban más rápido en presencia de radiación.
Ella llamó al fenómeno “radiosíntesis”, algo así como la fotosíntesis pero con radiación en vez de luz solar, y no cualquier radiación sino la ionizante es un millón de veces más energética que la luz blanca.

“Creemos que la melanina es capaz de transducir esa radiación en energía utilizable”, explicó Dadachova. Es decir, la melanina podría estar funcionando como un mini panel solar ultrapotente para hongos.
La hipótesis aún no está completamente demostrada, pero de ser cierta, es revolucionaria.
De Chernóbil al espacio
Si un hongo puede aprovechar la radiación en un sitio devastado, de inmediato los expertos se preguntaron qué podría hacer en lugares donde la radiación es enorme como el espacio.
Esto ha despertado el interés de científicos y agencias espaciales, el Dr. Arturo Casadevall, de la Universidad Johns Hopkins, explicó que la melanina podría convertirse en un escudo natural contra la radiación cósmica, uno de los grandes riesgos para los astronautas.
También puedes leer: Así lucen las ranas mutantes engendradas tras años de exposición a la radiación de Chernóbil
En 2018, una cepa de estos hongos, Cladosporium sphaerospermum, fue enviada a la Estación Espacial Internacional, y como resultado creció más rápido, aunque aún no se determina si la radiación fue la causa, el experimento mostró algo asombroso, una delgada capa del hongo podía bloquear parte de la radiación que recibía un sensor colocado debajo.
Este moho negro, sobreviviente en uno de los lugares más hostiles del planeta, podría terminar ayudando a limpiar zonas contaminadas como Chernóbil o Fukushima y quizá proteger a los humanos durante misiones a la Luna, Marte y más allá.
CONSULTA AQUÍ LAS NOTICIAS DE ÚLTIMA HORA
*brc